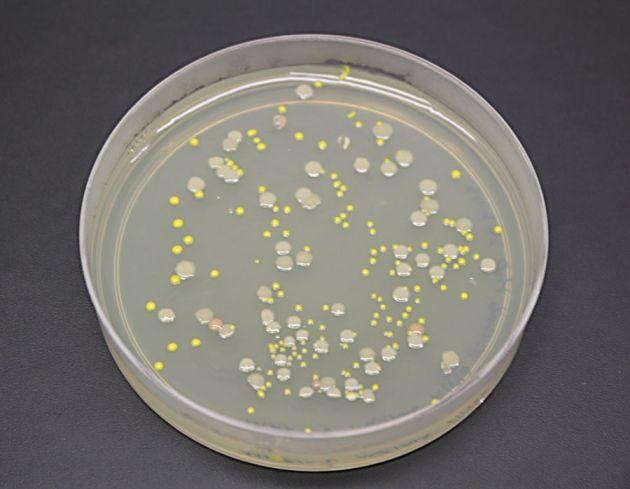

|
|
 发表于 2020-4-6 10:18:13
|
发表于 2020-4-6 10:18:13
|
查看: 544 |
回复: 0
要说地球上最神秘的区域,相信大家会报出一脸出人迹罕至的地方,比如珠穆朗玛峰顶、马里亚纳海沟,但南极厚厚的冰盖以下如果认了第一,可能就没有敢认第二的地方了!无疑被数公里厚冰块保护的南极冰下海洋,是地球上最无人知晓的地方!
神秘的冰下南极,科学家发现一个外星世界!
南极研究科学委员会在2006年的第五次国际会议上,确立了三个主要冰下湖的探测的,并且在解决外部生命污染带入冰下湖问题解决之前停止钻探,因此整个规划与湖泊勘探与问题解决总共持续了15年,从2011年开始继续进行钻探!南极主要有几个冰下湖,相应的钻探科研也有不同的国家担当:
美国——惠兰斯湖(Lake Whillans)俄罗斯——沃斯托克湖(Lake Vostok)英国——埃尔斯沃思湖(Lake Ellsworth)
俄罗斯沃斯托克冰湖的钻探方法非常具有典型意义,距离湖面50米换用一种消毒后的热钻头,避免细菌带入冰湖,等到钻入冰湖时立即拔出钻头,待湖水上涌冻结后在钻取冰芯!但事与愿违,俄罗斯这一波操作引发了“井喷”,因为沃斯托克湖受到了巨大的冰盖压力,所以当钻头钻入冰湖的一刹那,巨大的压力迫使湖水向上喷了数百米,队员们面面相觑,一脸懵逼,计算失误哈!
所以在喷出物中不可避免的混入了钻探过程中来不及撤离的钻探设备的防冻煤油以及润滑脂等,不过在解决了这些污染之后,俄罗斯科研团队在样本中发现了3507个基因序列,94%来自细菌、6%属于真核生物,湖中包含了复杂的生物网络,包括细菌、真菌和原核生物,甚至还有复杂的软体动物。
惠兰斯湖中的发现
与沃斯托克湖不一样,美国显然更务实,他们选择惠兰斯湖的距离冰面只有800米!而水深大约只有2米,看上去他们选定的位置似乎是惠兰斯湖的一个角落。蒙大拿州立大学的微生物生态学家约翰·普利斯库花了六年时间来设计采样设备,保证不会混入污染物,甚至工程师们都穿着无菌外套操作设备。
这短短的800米冰层只花了7天时间就搞定了,同样湖水因压力上升了几十米,冰下的水温是-0.5℃,2013年1月28日获得了第一份样品,有些淡黄色的海水样品,经过检测湖水中的菌类都是活的!在此后的一年间,从湖水中取得的样品分析出每毫升水体中还有13万个细胞,与深海微生物密度非常接近,DNA测序则显示了3900多种古细菌!
来自惠兰斯湖中的细菌培养后的菌落
检测显示并不能排除有高等生命存在的可能,但惠兰斯湖中有机物来源是个谜,因为此处几乎就是封闭的,海洋中的有机物要通过冰下通道到达这里,最乐观的估计需要6-7年,而这样的极端隔绝的环境中,这些生命能够存在几十万年绝对是一个奇迹!

南极冰下湖的分布
冰下湖的高级生命
当然科学家们并不满足于细菌生命,到了2015年1月,北伊利诺伊大学的冰川地质学家罗斯·鲍威尔带领的探险队带了一台水下机器人,在罗斯冰架的基线附近使用热水钻打了个740米深的洞,放下了水下机器人,结果让他们目瞪口呆,因为他们发现在暗无天日的封闭冰下海洋中,发现了鱼!在随后6小时的观察中,总共发现了20-30条小鱼,还有甲壳类动物,但很可惜没抓到鱼,不过捞了些不太会跑的红色端足目甲壳类动物!

冰下湖中的小鱼
而沃斯托克湖水体相对更大,甚至底部还有来自于地球内部的热量,在这个没有阳光,但却又巨大的水体以及热量提供的空间中,给人以无限想象的是木星的卫星系统和土星的卫星系统!木卫二和土卫二都有厚厚的冰层,以及存在一个潮汐引力提供热量的冰下海洋,南极冰下湖这个生态能存在这么久,那么很显然,木卫二和土卫二的海洋中也有可能存在大量的生命,甚至有可能发展到了相当高级!

冰下湖中红色端足目甲壳类动物!
NASA的欧罗巴快船计划
木卫二是木星的一颗表面覆盖了大量冰层的卫星,它和木卫一以及木卫三构成轨道共振态,在环绕木星公转的过程中,被木星引力时而撕裂,时而拉扯,内部产生了大量的热量,因此科学家相信在木卫二冰层下存在一个冰下海洋,这在1997年,伽利略木星探测器发现木卫二发现液态水的羽流中被证明!

欧罗巴冰下海洋
而欧罗巴快船是NASA和欧空局规划已久的专门探测木卫二的计划,但由于各种原因一直未能成行,而南极冰下的古细菌生态环境给了NASA最重要的信心!欧罗巴快船计划将不晚于2025年,将在数年内抵达木卫二,并且会释放一组探测器,包括能识别有机分子的生命探测仪等,也许过不了多久,我们就能在木卫二上发现太阳系另一个封闭的生态:木卫二生命圈!
原文地址:今日头条 |
|